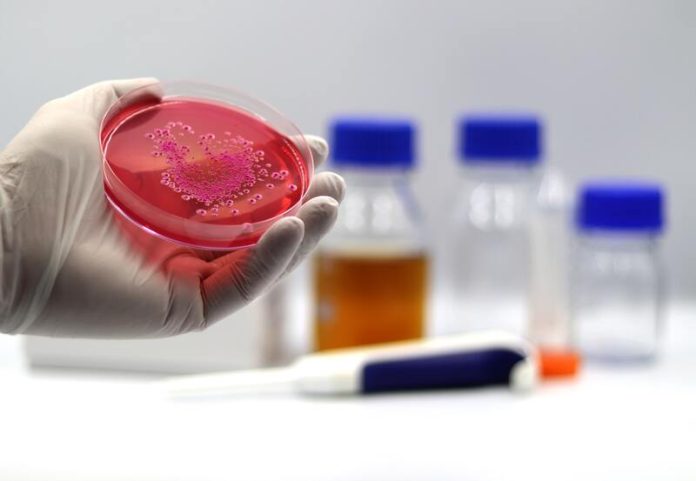
bactérie résistante antibiotiques antibiorésistance europe france alerte Ma Santé Un médecin qui examine les bactéries résistantes aux antibiotiques.

Il fut un temps où les antibiotiques étaient considérés comme des médicaments miracles. Une infection ? Une pilule, et le tour était joué. Mais aujourd’hui, ce scénario rassurant est en train de s’effriter. De plus en plus de bactéries apprennent à résister à ces traitements. Résultat : des maladies autrefois bénignes deviennent difficiles, voire impossibles à soigner.
Et en Europe, ce phénomène prend une ampleur inquiétante, au point de devenir un véritable enjeu de santé publique.
Une hausse alarmante des bactéries résistantes
L’Union européenne tire la sonnette d’alarme. D’après un rapport, publié par Linternaute Santé, les cas d’infections sanguines causées par Klebsiella pneumoniae résistante aux antibiotiques ont augmenté de 57 % entre 2019 et 2022 dans 23 pays membres. Cette bactérie, habituellement présente dans notre intestin sans danger, peut provoquer de graves infections : pneumonies, septicémies, voire décès.
Autre chiffre préoccupant : plus de 35 000 décès par an en Europe seraient liés directement à des infections résistantes aux antibiotiques, selon le Centre européen de prévention et de contrôle des maladies (ECDC).
Antibiorésistance : de quoi parle-t-on exactement ? Pourquoi les antibiotiques perdent-ils leur efficacité ?
La première cause souvent pointée du doigt, c’est la surconsommation d’antibiotiques. Que ce soit en médecine humaine, en médecine vétérinaire ou dans l’agroalimentaire, les antibiotiques et autres médicaments sont parfois utilisés de façon abusive ou inappropriée. Résultat : les bactéries s’adaptent, mutent, et deviennent plus résistantes.
Mais un point clé a récemment été soulevé par des chercheurs de l’Université d’Oxford, au Royaume-Uni : l’usage intensif des antibiotiques semble surtout jouer un rôle dans les phases initiales de l’apparition de la résistance. Après un certain niveau, la résistance atteint un palier, laissant penser que d’autres facteurs, encore mal connus, entrent en jeu. Leurs travaux ont été publiés dans la revue PLOS Pathogens et sont accessibles via PubMed Central.
Des technologies pour mieux détecter… et prévenir
Face à l’urgence, les chercheurs innovent. En Suisse, des scientifiques ont mis au point des capteurs ultrasensibles capables de cibler directement les bactéries ultrarésistantes. Ces dispositifs pourraient à terme permettre des diagnostics plus rapides et plus précis, et donc un traitement plus ciblé et efficace.
De son côté, l’Université de Lausanne développe un modèle d’intelligence artificielle (IA) appelé DIA, capable de mieux détecter les résistances bactériennes à partir de données cliniques. Une avancée qui pourrait révolutionner la prise en charge des infections graves.
L’approche “One Health” : une seule santé pour tous
La lutte contre l’antibiorésistance ne peut pas se faire en vase clos. C’est tout le principe du concept “One Health”, soutenu par l’OMS, qui prône une approche globale de la santé humaine, animale et environnementale.
Le laboratoire Resinfit, basé à Limoges, est à la pointe de cette stratégie. Il coordonne plusieurs projets européens pour limiter l’usage des antibiotiques, tout en surveillant de près les évolutions des résistances. Car oui, agir dès maintenant, c’est éviter que des infections aujourd’hui bénignes deviennent les fléaux de demain.
“Le risque, à terme, serait de perdre tous les progrès de la médecine moderne, si l’on n’était plus capable de traiter les infections. Une chirurgie banale comme la cataracte ne serait plus possible sans antibiotiques pour éviter l’infection oculaire“, explique le Dr Julien Textoris, directeur des affaires médicales chez bioMérieux, qui précise que selon une récente étude de l’OMS, “d’ici à 2050, il pourrait y avoir 39 millions de morts chaque année directement liés à la résistance aux antibiotiques“.
Ce que chacun peut faire au quotidien
En réalité, pas besoin d’être médecin pour adopter de bonnes pratiques et limiter les risques d’une antibiorésistance de votre organisme. Quelques gestes simples peuvent faire l’affaire :
- Ne jamais prendre d’antibiotiques sans ordonnance.
- Suivre scrupuleusement la durée du traitement prescrit.
- Ne jamais partager ses antibiotiques avec d’autres personnes.
- Préférer la vaccination quand elle existe (grippe, pneumocoque, etc.).
À SAVOIR
Malgré une baisse continue depuis 10 ans de la consommation d’antibiotiques en ville, la France reste le 4ᵉ pays européen le plus consommateur, derrière la Grèce, la Roumanie et la Bulgarie.


Ma Santé